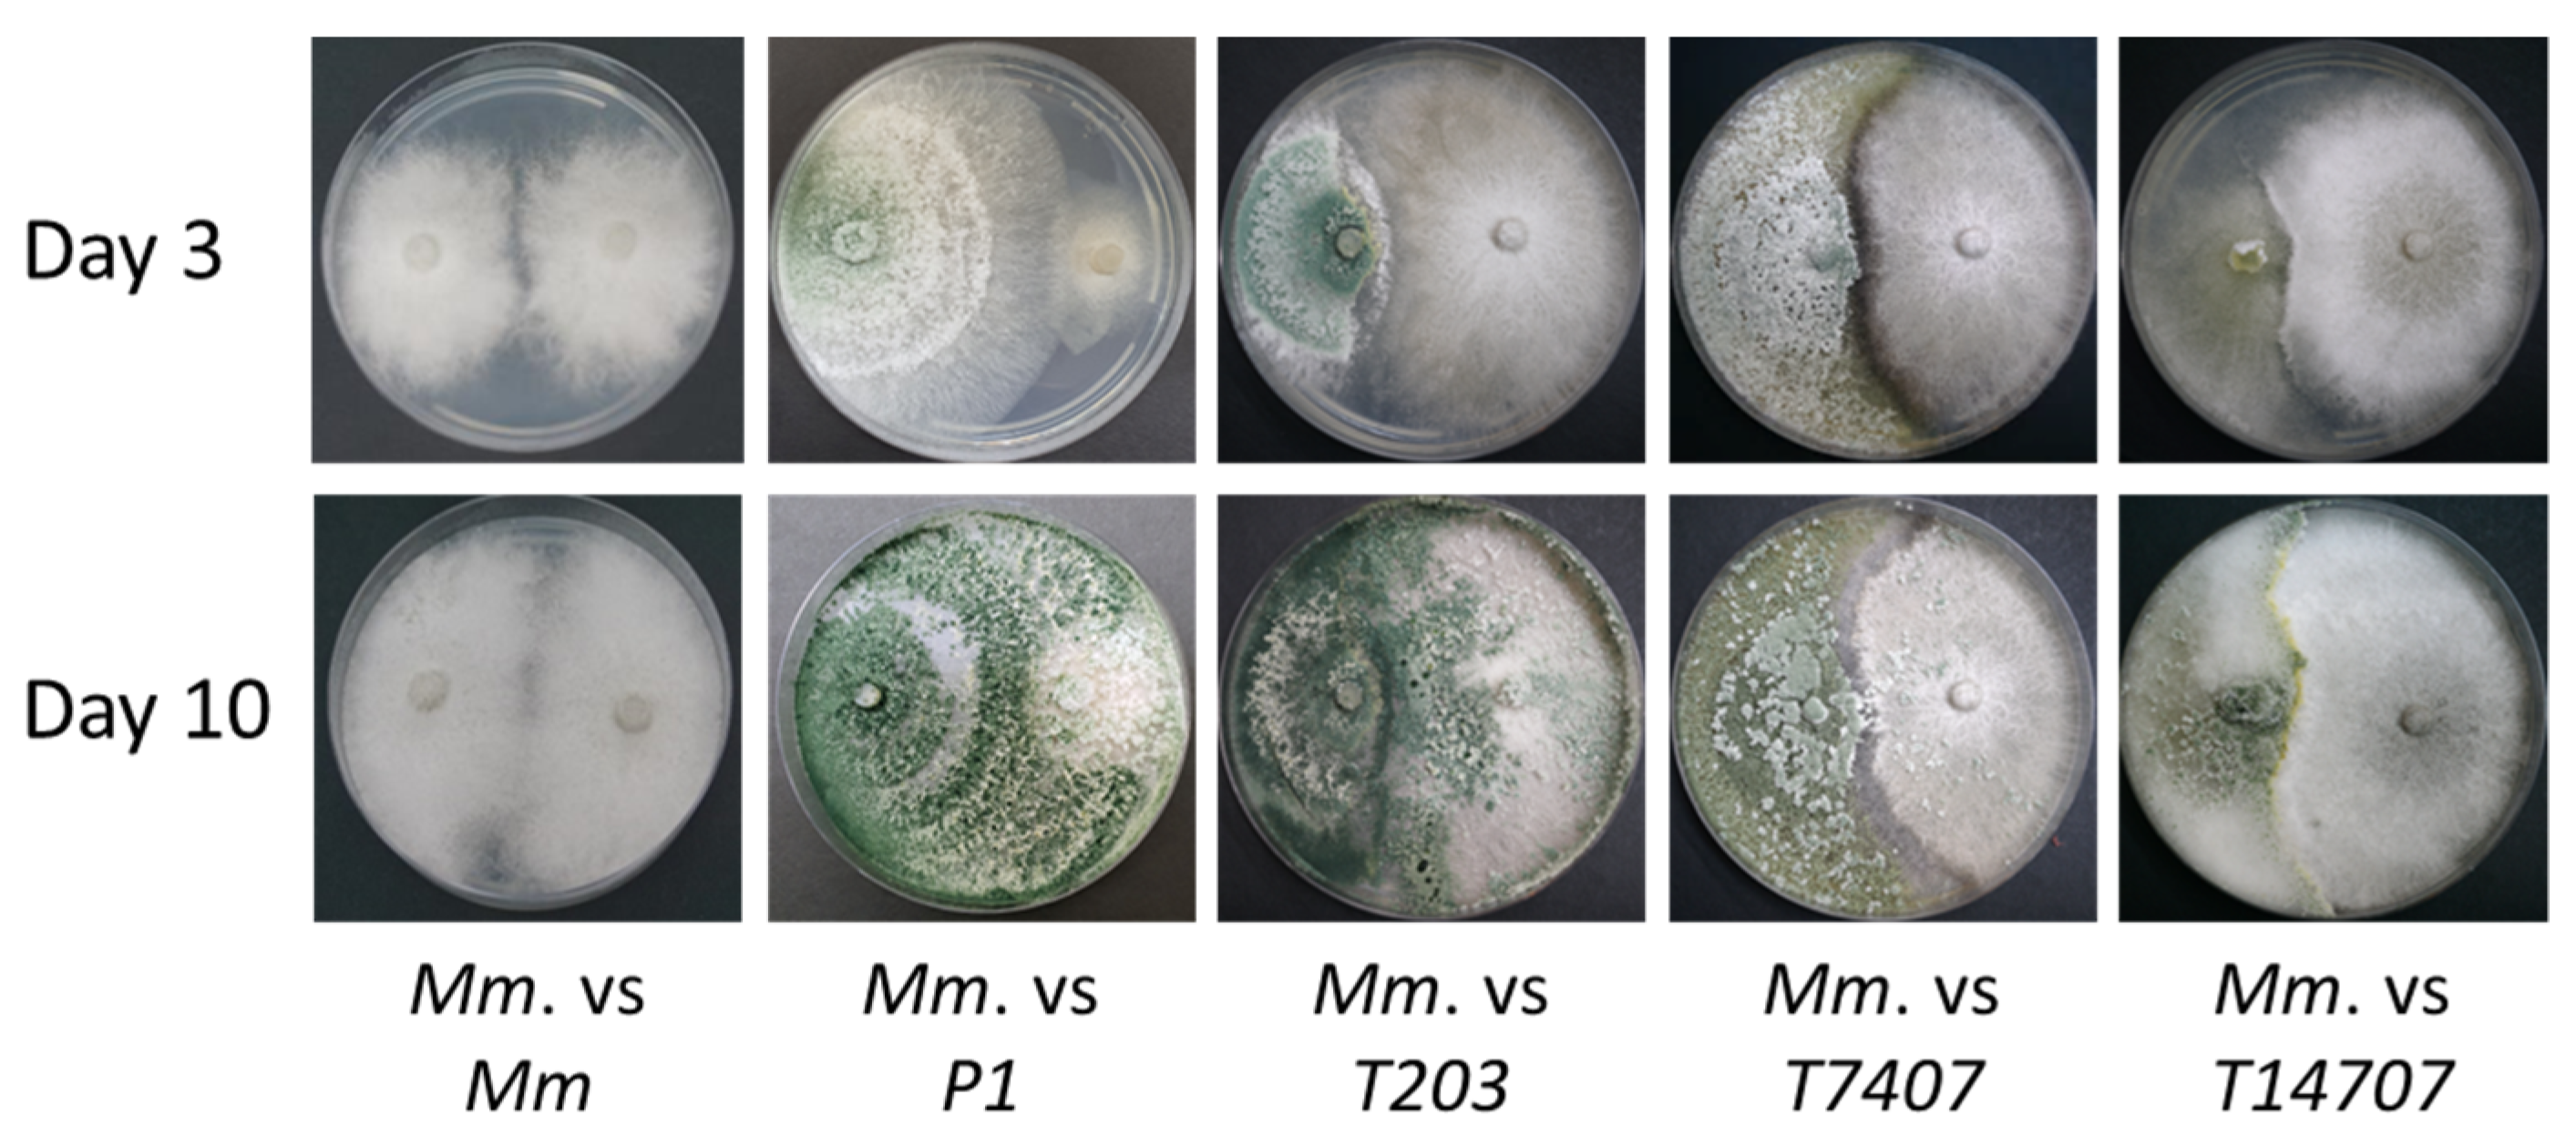

Integrated Biological and Chemical Control against the Maize Late Wilt Agent Magnaporthiopsis maydis
Abstract
1. Introduction
2. Materials and Methods
2.1. Rationale of the Study Design
2.2. Fungal Source and Growth Conditions
2.3. Azoxystrobin Inhibition Plates Assay
2.4. In Vitro Seed Assay
2.5. Growth Room Sprouts Assay
2.5.1. Preparation of Infected Sterilized Millet Grains
2.5.2. Magnaporthiopsis Maydis Infection and Protective Treatments
2.5.3. The Growth Room Assay Protocol
2.6. Whole-Season Pots Assay under Semi-Field Conditions
2.6.1. Growth Protocol and Conditions
2.6.2. Magnaporthiopsis Maydis Infection and Protective Treatments
2.6.3. Important Dates and Meteorological Data
2.6.4. Growth and Disease Estimation
2.7. Molecular Real-Time PCR Diagnostics
2.7.1. DNA Extraction
2.7.2. Real-Time PCR Technique
2.8. Statistical Analysis
3. Results
3.1. Azoxystrobin Inhibition Plates Assay
3.2. In Vitro Seed Assay
3.3. Growth Room Sprouts Assay
3.4. Whole-Season Pots Assay under Semi-Field Conditions
4. Discussion
5. Conclusions
Author Contributions
Funding
Institutional Review Board Statement
Informed Consent Statement
Data Availability Statement
Acknowledgments
Conflicts of Interest
References
- Klaubauf, S.; Tharreau, D.; Fournier, E.; Groenewald, J.; Crous, P.; de Vries, R.; Lebrun, M.-H. Resolving the polyphyletic nature of Pyricularia (Pyriculariaceae). Stud. Mycol. 2014, 79, 85–120. [Google Scholar] [CrossRef]
- Hernandez-Restrepo, M.; Groenewald, J.; Elliott, M.; Canning, G.; McMillan, V.; Crous, P.W. Take-all or nothing. Stud. Mycol. 2016, 83, 19–48. [Google Scholar] [CrossRef]
- Jiang, H.-B.; Hyde, K.D.; Yang, E.-F.; Kakumyan, P.; Bahkali, A.H.; Elgorban, A.M.; Karunarathna, S.C.; Phookamsak, R.; Lumyong, S. Morphological and phylogenetic appraisal of Ophioceras (Ophioceraceae, Magnaporthales). PLoS ONE 2021, 16, e0253853. [Google Scholar] [CrossRef]
- Elshahawy, I.E.; Khattab, A.E.-N.A. Endophyte Chaetomium globosum improves the growth of maize plants and induces their resistance to late wilt disease. J. Plant Dis. Prot. 2022, 129, 1125–1144. [Google Scholar] [CrossRef]
- El-Shenawy, A.A.; Hassan, M.A.A.; El-Haress, S.M.A.; Abd-Elaziz, M.A.A. Assessment of Combining Ability in Some Newly Maize Inbred Lines for Grain Yield and Late Wilt Resistance. J. Plant Prod. 2022, 13, 45–48. [Google Scholar] [CrossRef]
- Degani, O.; Chen, A.; Dor, S.; Orlov-Levin, V.; Jacob, M.; Shoshani, G.; Rabinovitz, O. Remote evaluation of maize cultivars susceptibility to late wilt disease caused by Magnaporthiopsis maydis. J. Plant Pathol. 2022, 104, 509–525. [Google Scholar] [CrossRef]
- Ortiz-Bustos, C.M.; López-Bernal, A.; Testi, L.; Molinero-Ruiz, L. Environmental and irrigation conditions can mask the effect of Magnaporthiopsis maydis on growth and productivity of maize. Plant Pathol. 2019, 68, 1555–1564. [Google Scholar] [CrossRef]
- Patanita, M.; Campos, M.D.; Félix, M.D.R.; Carvalho, M.; Brito, I. Effect of Tillage System and Cover Crop on Maize Mycorrhization and Presence of Magnaporthiopsis maydis. Biology 2020, 9, 46. [Google Scholar] [CrossRef]
- Rakesh, B.; Gangappa, E.; Gandhi, S.; Gowda, R.P.V.; Swamy, S.D.; Ramesh, S.; Hemareddy, H.B. Mapping genomic regions controlling resistance to late wilt disease caused by Harpophora maydis in maize (Zea mays L.). Euphytica 2022, 218, 101. [Google Scholar] [CrossRef]
- Saleh, A.A.; Leslie, J.F. Cephalosporium maydis is a distinct species in the Gaeumannomyces-Harpophora species complex. Mycologia 2004, 96, 1294–1305. [Google Scholar] [CrossRef]
- Sabet, K.A.; Samra, A.S.; Mansour, I.M.; Zaher, A.M. Pathogenic behaviour of Cephalosporium maydis and C. acremonium. Ann. Appl. Biol. 1970, 66, 257–263. [Google Scholar] [CrossRef]
- Agag, S.H.; Sabry, A.M.; El-Samman, M.G.; Mostafa, M.H. Pathological and Molecular Characterization of Magnaporthiopsis maydis Isolates Causing Late Wilt in Maize. Egypt. J. Phytopathol. 2021, 49, 1–9. [Google Scholar] [CrossRef]
- Johal, L.; Huber, D.M.; Martyn, R. Late Wilt of Corn (Maize) Pathway Analysis: Intentional Introduction of Cephalosporium maydis. In Pathways Analysis for the Introduction to the U.S. of Plant Pathogens of Economic Importance; Purdue University West Lafayette: West Lafayette, IN, USA, 2004. [Google Scholar]
- Sabet, K.A.; Samra, A.S.; Mansour, I.M. Saprophytic behaviour of Cephalosporium maydis and C. acremonium. Ann. Appl. Biol. 1970, 66, 265–271. [Google Scholar] [CrossRef]
- Michail, S.H.; Abou-Elseoud, M.S.; Nour Eldin, M.S. Seed health testing of corn for Cephalosporium maydis. Acta Phytopathol. Entomol. Hung. 1999, 34, 35–42. [Google Scholar]
- Drori, R.; Sharon, A.; Goldberg, D.; Rabinovitz, O.; Levy, M.; Degani, O. Molecular diagnosis for Harpophora maydis, the cause of maize late wilt in Israel. Phytopathol. Mediterr. 2013, 52, 16–29. [Google Scholar] [CrossRef]
- Samra, A.S.; Sabet, K.A.; Hingorani, M.K. A new wilt disease of maize in Egypt. Plant Dis. Rep. 1962, 46, 481–483. [Google Scholar]
- Degani, O. A Review: Late Wilt of Maize—The Pathogen, the Disease, Current Status and Future Perspective. J. Fungi 2021, 7, 989. [Google Scholar] [CrossRef] [PubMed]
- Degani, O.; Becher, P.; Gordani, A. Pathogenic Interactions between Macrophomina phaseolina and Magnaporthiopsis maydis in Mutually Infected Cotton Sprouts. Agriculture 2022, 12, 255. [Google Scholar] [CrossRef]
- Samra, A.; Sabet, K.; Kamel, M.; Abd El-Rahim, M. Further Studies on the Effect of Field Conditions and Cultural Practices on Infection with Stalk-Rot Complex of Maize; Arab Republic of Egypt, Min. of Agriculture, Plant Protection Department: Cairo, Egypt, 1971; Available online: http://library.wur.nl/webquery/clc/385177 (accessed on 31 December 2022).
- Payak, M.; Sharma, R. Research on Diseases of Maize; Indian Council of Agricultural Research: New Delhi, India, 1978; p. 228. [Google Scholar]
- Degani, O.; Movshowitz, D.; Dor, S.; Meerson, A.; Goldblat, Y.; Rabinovitz, O. Evaluating Azoxystrobin Seed Coating Against Maize Late Wilt Disease Using a Sensitive qPCR-Based Method. Plant Dis. 2019, 103, 238–248. [Google Scholar] [CrossRef]
- Degani, O.; Weinberg, T.; Graph, S. Chemical control of maize late wilt in the field. Phytoparasitica 2014, 42, 559–570. [Google Scholar] [CrossRef]
- Abd El-Rahim, M.F.; Fahmy, G.M.; Fahmy, Z.M. Alterations in transpiration and stem vascular tissues of two maize cultivars under conditions of water stress and late wilt disease. Plant Pathol. 1998, 47, 216–223. [Google Scholar] [CrossRef]
- Samra, A.S.; Sabet, K.A.; Abd El-Rahim, M.F. Effect of Soil Conditions and Cultural Practices on Infection with Stalk Rots; U.A.R. Ministry of Agric. Government Printing Offices: Cairo, Egypt, 1966; pp. 117–164. [Google Scholar]
- El-Shafey, H.A.; El-Shorbagy, F.A.; Khalil, I.I.; El-Assiuty, E.M. Additional sources of resistance to the late-wilt disease of maize caused by Cephalosporium maydis. Agric. Res. Rev. Egypt 1988, 66, 221–230. [Google Scholar]
- Singh, S.D.; Siradhana, B.S. Date of sowing in relation to late wilt disease of maize. Indian Phytopathol. 1988, 41, 489–491. [Google Scholar]
- Sunitha, N.C.; Gangappa, E.; Gowda, R.P.V.; Ramesh, S.; Biradar, S.; Swamy, D.; Hemareddy, H.B. Discovery of genomic regions associated with resistance to late wilt disease caused by Harpophora maydis (Samra, Sabet and Hing) in maize (Zea mays L.). J. Appl. Genet. 2021, 63, 185–197. [Google Scholar] [CrossRef]
- Kumar, K.A.; Gangappa, E.; Swamy, S.R.A.D.S. Identification of high yielding inbred lines resistant to late wilt disease caused by Harpophora maydis in maize. Electron. J. Plant Breed. 2021, 12, 151–158. [Google Scholar] [CrossRef]
- Kamara, M.; Ghazy, N.; Mansour, E.; Elsharkawy, M.; Kheir, A.; Ibrahim, K. Molecular Genetic Diversity and Line × Tester Analysis for Resistance to Late Wilt Disease and Grain Yield in Maize. Agronomy 2021, 11, 898. [Google Scholar] [CrossRef]
- Gazala, P.; Gangappa, E.; Ramesh, S.; Swamy, D. Comparative Breeding potential of two crosses for response to late wilt disease (LWD) in maize (Zea mays L.). Genet. Resour. Crop Evol. 2021, 68, 1751–1757. [Google Scholar] [CrossRef]
- Sunitha, N.; Gangappa, E.; Gowda, R.V.; Ramesh, S.; Swamy, S.D.; Hemareddy, H. Effectiveness of one cycle of phenotype-based backcross breeding for resistance to late wilt disease in maize (Zea mays L.). Mysore J. Agric. Sci. 2020, 54, 47–50. [Google Scholar]
- Degani, O.; Yifa, R.; Gordani, A.; Becher, P.; Chen, A. Cultivars Resistance Assay for Maize Late Wilt Disease. Biology 2022, 11, 1854. [Google Scholar] [CrossRef]
- Zeller, K.A.; Ismael, A.-S.M.; El-Assiuty, E.M.; Fahmy, Z.M.; Bekheet, F.M.; Leslie, J.F. Relative Competitiveness and Virulence of Four Clonal Lineages of Cephalosporium maydis from Egypt Toward Greenhouse-Grown Maize. Plant Dis. 2002, 86, 373–378. [Google Scholar] [CrossRef]
- Shofman, G.; Bahouth, M.; Degani, O. Aggressive strains of the late wilt fungus of corn exist in Israel in mixed populations and can specialize in disrupting growth or plant health. Fungal Biol. 2022, 126, 793–808. [Google Scholar] [CrossRef] [PubMed]
- García-Carneros, A.B.; Girón, I.; Molinero-Ruiz, L. Aggressiveness of Cephalosporium maydis causing late wilt of maize in Spain. Commun. Agric. Appl. Biol. Sci. 2011, 77, 173–179. [Google Scholar]
- Ortiz-Bustos, C.M.; Testi, L.; García-Carneros, A.B.; Molinero-Ruiz, L. Geographic distribution and aggressiveness of Harpophora maydis in the Iberian peninsula, and thermal detection of maize late wilt. Eur. J. Plant Pathol. 2015, 144, 383–397. [Google Scholar] [CrossRef]
- Degani, O. Control Strategies to Cope with Late Wilt of Maize. Pathogens 2022, 11, 13. [Google Scholar] [CrossRef] [PubMed]
- Abd El-Rahim, M.F.; Sabet, K.A.; El-Shafey, H.A.; El-Assiuty, E.M. Chemical control of the late-wilt disease of maize caused by Cephalosporium maydis. Agric. Res. Rev. 1982, 60, 31–49. [Google Scholar]
- Degani, O.; Dor, S.; Chen, A.; Orlov-Levin, V.; Stolov-Yosef, A.; Regev, D.; Rabinovitz, O. Molecular Tracking and Remote Sensing to Evaluate New Chemical Treatments Against the Maize Late Wilt Disease Causal Agent, Magnaporthiopsis maydis. J. Fungi 2020, 6, 54. [Google Scholar] [CrossRef]
- Singh, S.D.; Siradhana, B.S. Chemical control of late wilt of maize induced by Cephalosporium maydis. Indian J. Mycol. Plant Path. 1989, 19, 121–122. [Google Scholar]
- El-Shafey, H.; Dawood, N.A.; Ibrahim, T.; Mahmoud, S.; El-Bordfasy, M. Antagonism between Soil Microflora and Late-Wilt of Maize Fungus Cephalosporium maydis [Egypt]. In Proceedings of the 4th Egyptian Conference of Botany, Ismaileyah, Egypt, 16–19 April 1985. [Google Scholar]
- Degani, O.; Danielle, R.; Dor, S. The Microflora of Maize Grains as a Biological Barrier against the Late Wilt Causal Agent, Magnaporthiopsis maydis. Agronomy 2021, 11, 965. [Google Scholar] [CrossRef]
- Gal-Hemed, I.; Atanasova, L.; Komon-Zelazowska, M.; Druzhinina, I.S.; Viterbo, A.; Yarden, O. Marine Isolates of Trichoderma spp. as Potential Halotolerant Agents of Biological Control for Arid-Zone Agriculture. Appl. Environ. Microbiol. 2011, 77, 5100–5109. [Google Scholar] [CrossRef]
- El-Assiuty, E.M.; El-Hamahmy, A.A.; El-Sharkawy, A.Y. Bacillus subtilis, Pseudomonas fluorescens and Verticillium tricorpus as biological agents against late-wilt of maize. Egypt. J. Appl. Sci. 1991, 6, 8245–8829. [Google Scholar]
- Ghazy, N.; El-Nahrawy, S. Siderophore production by Bacillus subtilis MF497446 and Pseudomonas koreensis MG209738 and their efficacy in controlling Cephalosporium maydis in maize plant. Arch. Microbiol. 2020, 203, 1195–1209. [Google Scholar] [CrossRef] [PubMed]
- El-Assiuty, E.; Abd El-Moity, T.; El-Shaafey, H. Mycoparasitic effect of Trichoderma harzianum Rifai against Cephalosporium acremonium Corda. Egypt. J. Microb. 1986, 21, 111–116. [Google Scholar]
- Elshahawy, I.E.; El-Sayed, A.E.-K.B. Maximizing the efficacy of Trichoderma to control Cephalosporium maydis, causing maize late wilt disease, using freshwater microalgae extracts. Egypt. J. Biol. Pest Control 2018, 28, 48. [Google Scholar] [CrossRef]
- Abdel-Kader, M.; Khalil, M.; El-Mougy, N. Efficacy of fungicide alternatives against late wilt disease of maize and their influence on plant morphogenesis and yield characters. Hell. Plant Prot. J. 2022, 15, 57–71. [Google Scholar] [CrossRef]
- Degani, O.; Dor, S. Trichoderma Biological Control to Protect Sensitive Maize Hybrids against Late Wilt Disease in the Field. J. Fungi 2021, 7, 315. [Google Scholar] [CrossRef] [PubMed]
- Degani, O.; Rabinovitz, O.; Becher, P.; Gordani, A.; Chen, A. Trichoderma longibrachiatum and Trichoderma asperellum Confer Growth Promotion and Protection against Late Wilt Disease in the Field. J. Fungi 2021, 7, 444. [Google Scholar] [CrossRef] [PubMed]
- Howell, C.R. Mechanisms Employed by Trichoderma Species in the Biological Control of Plant Diseases: The History and Evolution of Current Concepts. Plant Dis. 2003, 87, 4–10. [Google Scholar] [CrossRef] [PubMed]
- Legrand, F.; Picot, A.; Cobo-Díaz, J.F.; Chen, W.; Le Floch, G. Challenges facing the biological control strategies for the management of Fusarium Head Blight of cereals caused by F. graminearum. Biol. Control 2017, 113, 26–38. [Google Scholar] [CrossRef]
- Malik, V.K.; Singh, M.; Hooda, K.S.; Yadav, N.K.; Chauhan, P.K. Efficacy of Newer Molecules, Bioagents and Botanicals against Maydis Leaf Blight and Banded Leaf and Sheath Blight of Maize. Plant Pathol. J. 2018, 34, 121–125. [Google Scholar] [CrossRef]
- Ons, L.; Bylemans, D.; Thevissen, K.; Cammue, B.P.A. Combining Biocontrol Agents with Chemical Fungicides for Integrated Plant Fungal Disease Control. Microorganisms 2020, 8, 1930. [Google Scholar] [CrossRef]
- Wang, S.Q.; Jia, M.A.; Wang, M.; Wang, X.H.; Li, Y.Q.; Jie, C. Combined application of Trichoderma harzianum SH2303 and difenoconazole-propiconazolein controlling southern corn leaf blight disease caused by Cochliobolus heterostrophus in maize. J. Integr. Agric. 2019, 18, 2063–2071. [Google Scholar] [CrossRef]
- Degani, O.; Dor, S.; Movshovitz, D.; Rabinovitz, O. Methods for Studying Magnaporthiopsis maydis, the Maize Late Wilt Causal Agent. Agronomy 2019, 9, 181. [Google Scholar] [CrossRef]
- Degani, O.; Dor, S.; Movshowitz, D.; Fraidman, E.; Rabinovitz, O.; Graph, S. Effective chemical protection against the maize late wilt causal agent, Harpophora maydis, in the field. PLoS ONE 2018, 13, e0208353. [Google Scholar] [CrossRef] [PubMed]
- Degani, O.; Gordani, A. New Antifungal Compound, 6-Pentyl-α-Pyrone, against the Maize Late Wilt Pathogen, Magnaporthiopsis maydis. Agronomy 2022, 12, 2339. [Google Scholar] [CrossRef]
- Samuels, G.J.; Ismaiel, A.; Bon, M.-C.; De Respinis, S.; Petrini, O. Trichoderma asperellum sensu lato consists of two cryptic species. Mycologia 2010, 102, 944–966. [Google Scholar] [CrossRef]
- Murray, M.G.; Thompson, W.F. Rapid isolation of high molecular weight plant DNA. Nucleic Acids Res. 1980, 8, 4321–4326. [Google Scholar] [CrossRef]
- Yuan, J.S.; Reed, A.; Chen, F.; Stewart, C.N.J. Statistical analysis of real-time PCR data. BMC Bioinform. 2006, 7, 85. [Google Scholar] [CrossRef]
- Livak, K.J.; Schmittgen, T.D. Analysis of relative gene expression data using real-time quantitative PCR and the 2−ΔΔCT Method. Methods 2001, 25, 402–408. [Google Scholar] [CrossRef]
- Li, W.; Hartung, J.S.; Levy, L. Quantitative real-time PCR for detection and identification of Candidatus Liberibacter species associated with citrus huanglongbing. J. Microbiol. Methods 2006, 66, 104–115. [Google Scholar] [CrossRef]
- Weller, S.A.; Elphinstone, J.G.; Smith, N.C.; Boonham, N.; Stead, D.E. Detection of Ralstonia solanacearum Strains with a Quantitative, Multiplex, Real-Time, Fluorogenic PCR (TaqMan) Assay. Appl. Environ. Microbiol. 2000, 66, 2853–2858. [Google Scholar] [CrossRef]
- Shalaby, M.; El-Moghazy, S.; Mehesen, A.A. Biological control of maize late wilt disease caused by Cephalosporium maydis. J. Agric. Res. Kafrelsheikh Univ. 2009, 35, 1–19. [Google Scholar]
- Payak, M.M.; Lal, S.; Lilaramani, J.; Renfro, B.L. Cephalosporium maydis—A new threat to maize in India. Indian Phytopathol. 1970, 23, 562–569. [Google Scholar]
- Pecsi, S.; Nemeth, L. Appearance of Cephalosporium maydis Samra Sabet and Hingorani in Hungary. Meded. Fac. Landbouwkd. Toegep. Biol. Wet. Univ. Gent. 1998, 63, 873–877. [Google Scholar]
- Abbas, M.; Saleem, M.; Hussain, D.; Ramzan, M.; Abbas, S.; Hussain, N.; Irshad, M.; Hussain, K.; Ghouse, G.; Khaliq, M.; et al. Review on integrated disease and pest management of field crops. Int. J. Trop. Insect Sci. 2022, 42, 3235–3243. [Google Scholar] [CrossRef]
- Ferreira, F.V.; Musumeci, M.A. Trichoderma as biological control agent: Scope and prospects to improve efficacy. World J. Microbiol. Biotechnol. 2021, 37, 90. [Google Scholar] [CrossRef] [PubMed]
- Bastakoti, S.; Belbase, S.; Manandhar, S.; Arjyal, C. Trichoderma species as Biocontrol Agent against Soil Borne Fungal Pathogens. Nepal J. Biotechnol. 2017, 5, 39–45. [Google Scholar] [CrossRef]
- Harman, G.E. Overview of Mechanisms and Uses of Trichoderma spp. Phytopathology 2006, 96, 190–194. [Google Scholar] [CrossRef]
- Harman, G.E.; Howell, C.R.; Viterbo, A.; Chet, I.; Lorito, M. Trichoderma species—Opportunistic, avirulent plant symbionts. Nat. Rev. Genet. 2004, 2, 43–56. [Google Scholar] [CrossRef]
- Degani, O.; Khatib, S.; Becher, P.; Gordani, A.; Harris, R. Trichoderma asperellum Secreted 6-Pentyl-α-Pyrone to Control Magnaporthiopsis maydis, the Maize Late Wilt Disease Agent. Biology 2021, 10, 897. [Google Scholar] [CrossRef]
- Francl, L.J. The Disease Triangle: A Plant Pathological Paradigm Revisited. Plant Health Instr. 2001, 10, 1094. [Google Scholar] [CrossRef]
- Abd-El-Khair, H.; Elshahawy, I.E.; Haggag, H.E.K. Field application of Trichoderma spp. combined with thiophanate-methyl for controlling Fusarium solani and Fusarium oxysporum in dry bean. Bull. Natl. Res. Cent. 2019, 43, 19. [Google Scholar] [CrossRef]
- Ruano-Rosa, D.; Arjona-Girona, I.; López-Herrera, C. Integrated control of avocado white root rot combining low concentrations of fluazinam and Trichoderma spp. Crop Prot. 2018, 112, 363–370. [Google Scholar] [CrossRef]
- Elad, Y.; Zimand, G.; Zaqs, Y.; Zuriel, S.; Chet, I. Use of Trichoderma harzianum in combination or alternation with fungicides to control cucumber grey mould (Botrytis cinerea) under commercial greenhouse conditions. Plant Pathol. 1993, 42, 324–332. [Google Scholar] [CrossRef]
- Khirallah, W.; Mouden, N.; Selmaoui, K.; Achbani, E.; Benkirane, R.; Touhami, A.O.; Douira, A. Compatibility of Trichoderma spp. with some fungicides under in vitro conditions. Int. J. Recent Sci. Res. 2016, 7, 9060–9067. [Google Scholar]
- Wojtkowiak-Gębarowska, E.; Pietr, S. Colonization of roots and growth stimulation of cucumber by iprodione-resistant isolates of Trichoderma spp. applied alone and combined with fungicides. Phytopathol. Pol 2006, 41, 51–64. [Google Scholar]
- Zin, N.A.; Badaluddin, N.A. Biological functions of Trichoderma spp. for agriculture applications. Ann. Agric. Sci. 2020, 65, 168–178. [Google Scholar] [CrossRef]

| Species | Designation | Origin | Reference | Role |
|---|---|---|---|---|
| Trichoderma asperelloides | T203 | ATCC 36042, CBS 396.92 | [50,60] | M. maydis antagonist |
| Trichoderma asperellum | P1 | Zea mays, Prelude cv. | [43] | M. maydis antagonist |
| Trichoderma longibrachiatum | T7407 | Psammocinia sp. 1 | [44,50] | M. maydis antagonist |
| Trichoderma sp. O.Y. 14707 | T14707 | Psammocinia sp. 1 | [44] | Control (non-influencing) |
| Date | Inoculation, Planting and Sprouting Assessment | Days from Sowing |
|---|---|---|
| 19/07/2022 | 1st inoculation (sterilized infected millet grains) | −7 |
| 02/08/2022 | Sowing and 2nd inoculation (three discs/seed) | 0 |
| 09/08/2022 | Aboveground sprouting | 7 |
| 11/08/2022 | 3rd inoculation (three discs/sprout) and soil surface peek evaluation | 9 |
| Pesticide treatments | ||
| 17/08/2022 | Pesticide I | 15 |
| 01/09/2022 | Pesticide II (15 days from Pesticide I) | 30 |
| 15/09/2022 | Pesticide III (14 days from Pesticide II) | 44 |
| Sampling and harvest | ||
| 11/09/2022 | Midseason sampling and thinning | 40 |
| 21/09/2022 | Male flowering peak | 50 |
| 01/10/2022 | End of fertilization period growth estimation | 61 |
| 19/10/2022 | Harvest and final sampling | 78 |
| Parameters | Value |
|---|---|
| Dates | 02/08/2022–19/10/2022 |
| Temperature (°C) | 26.6 ± 5.5 |
| Humidity (%) | 61.9 ± 16.9 |
| Soil temp. top 5 cm (°C) | 30.4 ± 4.1 |
| Radiation (W/m2) | 238.3 |
| Precipitation (mm) | 4.6 |
| Evaporation (mm) | 457.7 |
| Pairs | Primer | Sequence | Uses | Amplification | References |
|---|---|---|---|---|---|
| Pair 1 | A200a-for A200a-rev | 5′-CCGACGCCTAAAATACAGGA-3′ 5′-GGGCTTTTTAGGGCCTTTTT-3′ | Target gene | 200 bp M. maydis species-specific fragment, qPCR cycling—27 or above | [16] |
| Pair 3 | COX-F COX-R | 5′-GTATGCCACGTCGCATTCCAGA-3′ 5′-CAACTACGGATATATAAGRRCCRR AACTG-3′ | Control | Cytochrome C oxidase (COX) gene product, qPCR cycling—27 or below | [64,65] |
Disclaimer/Publisher’s Note: The statements, opinions and data contained in all publications are solely those of the individual author(s) and contributor(s) and not of MDPI and/or the editor(s). MDPI and/or the editor(s) disclaim responsibility for any injury to people or property resulting from any ideas, methods, instructions or products referred to in the content. |
© 2023 by the authors. Licensee MDPI, Basel, Switzerland. This article is an open access article distributed under the terms and conditions of the Creative Commons Attribution (CC BY) license (https://creativecommons.org/licenses/by/4.0/).
Share and Cite
Gordani, A.; Hijazi, B.; Dimant, E.; Degani, O. Integrated Biological and Chemical Control against the Maize Late Wilt Agent Magnaporthiopsis maydis. Soil Syst. 2023, 7, 1. https://doi.org/10.3390/soilsystems7010001
Gordani A, Hijazi B, Dimant E, Degani O. Integrated Biological and Chemical Control against the Maize Late Wilt Agent Magnaporthiopsis maydis. Soil Systems. 2023; 7(1):1. https://doi.org/10.3390/soilsystems7010001
Chicago/Turabian StyleGordani, Asaf, Bayan Hijazi, Elhanan Dimant, and Ofir Degani. 2023. "Integrated Biological and Chemical Control against the Maize Late Wilt Agent Magnaporthiopsis maydis" Soil Systems 7, no. 1: 1. https://doi.org/10.3390/soilsystems7010001
APA StyleGordani, A., Hijazi, B., Dimant, E., & Degani, O. (2023). Integrated Biological and Chemical Control against the Maize Late Wilt Agent Magnaporthiopsis maydis. Soil Systems, 7(1), 1. https://doi.org/10.3390/soilsystems7010001

